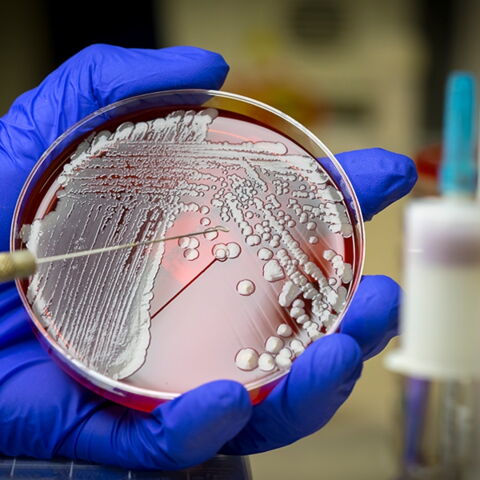
Darum wirst du häufiger von Mücken gestochen

Mücken-Opfer: Darum wirst du häufiger als andere von Mücken gestochen

Falls du gerne Bier trinkst, erwischt es dich vielleicht besonders oft. Biertrinker schwitzen mehr und scheiden mehr Kohlendioxid aus. Das gefällt Mücken sehr gut und lockt sie an.

Mücken sind große Hitzefans. Je höher deine Körpertemperatur, desto besser für die Tiere. Sie gehen dann besonders gerne zum Angriff über.